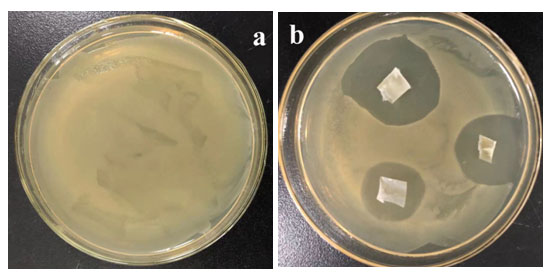

| 地址: | 遼寧省沈陽市渾南區汪家街道大甸子工業園24號 |
| 業務: | 18940211048 |
| 監督: | 18940211048 |
| 傳真: | 024-24748450 |


抗菌水管
一直以來,環保問題都是全世界、全人類所關注的重點問題,這些年來,國家多次出臺相關政策,希望治理好環境問題。尤其是近幾年來,水管污染問題越來越引起大家的重視。水管污染主要是指水在水管中的長時間靜止,或者管道水流速緩慢或者長時間使用后,水管內壁容易出現污垢積累,甚至長青苔的現象發生,同時會滋生大量的金黃色葡萄球菌、大腸桿菌等細菌,會直接危害人體健康。"世界衛生組織調查顯示,80%疾病與水污染及飲水不當有關。"此外疾控專家表示,傷寒、痢疾、胃腸炎、傳染性肝病等傳染性疾病都可由不潔凈的水引起。
越來越多人也認識到,水管其實并沒有我們想象得那么干凈衛生,相反,管道中其實藏匿著各種污垢和細菌以及隨之帶來的更多麻煩,因污垢和細菌引起的水管流黃水、水質超標、自來水有異味、洗完澡干癢難受、水管易堵塞以及后續水管不易更換、不易清潔等難題。如下圖所示:

為解決上述問題,本公司研發了一種生活用水抗菌水管,具備高效和長效的抗菌性能。具備以下優點:一、本抗菌水管設置有玻璃纖維網層,使得水管抗拉伸、強度大、膨脹系數小,相較于市面上水管,本發明提供的抗菌水管在使用過程中不易變形和彎曲。二、內側抗菌涂層能有效消滅金黃色葡萄球菌、大腸桿菌等達到抗菌效果,對水管內部起到很好的自清潔作用,減少生活水管的清洗頻率或者降低更換周期,節約成本,具備高效抗菌性。三、抗菌涂層是抗菌劑和PE材料的復合材料,因此抗菌劑在使用過程中不易剝離或流失,抗菌周期長,使用壽命長,具備長效抗菌性。
圖1. 培養基培養24小時后抗菌水管抑菌圈測試效果圖(a:對照樣;b:放置抗菌水管片樣)
本公司研發的抗菌水管內側塑料片具備優良的抗菌性能。圖1培養基培養24小時后抗菌水管抑菌圈測試效果圖。測試結果表明,經24小時后,相比于空白對照樣,抗細菌塑料管片附近出現明顯的抑菌圈,說明本公司產品具備優良的抗細菌性能。
圖2是委托具備CMA、CNAS等資質的廣東省微生物分析檢測中心檢測,依據JC/T939-2004標準測試其抗菌性能得到的測試結果。測試結果表明,經24小時后,抗細菌塑料管樣抗菌率達到99.99%以上,說明我們的抗菌水管具備優良的抗細菌性能。

圖2. 依據JC/T939-2004標準測試其抗菌性能得到的測試結果
上一篇:沒有了
下一篇:PE礦用管系列


